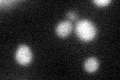
YNL328C
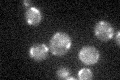
YNL328C

View description
Constituent of the mitochondrial import motor associated with the presequence translocase; function overlaps with that of Pam18p; stimulates the ATPase activity of Ssc1p to drive mitochondrial import; contains a J domain
Localization:
Intensity:
Fold change:
Significance:
-
C’ GFP library in SD

mitochondria24.01 -
N' NOP1pr-GFP in SD

below threshold24.5177 -
N' TEF2pr-mCherry in SD

cytosol9.67708 -
N' NATIVEpr-GFP in SD

below threshold19.1763 -
N' TEF2pr-VC and Cyto-VN in SD

below threshold24.9734 -
C’ GFP library in SD+DTT
mitochondria21.830.9No -
C’ GFP library in SD+H2O2
mitochondria18.810.78Yes -
C’ GFP library in Starvation Media

mitochondria19.140.79No -
C’ GFP library on the background of Pup2-DaMP

mitochondria -
C’ GFP library on the background of CCT mutant

mitochondria18.79090.782385No
